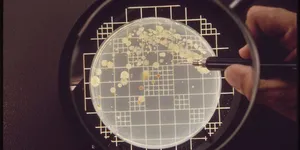
CFU là gì? Cách tính CFU như thế nào?

NaOH là gì? Tính chất, cách điều chế và ứng dụng của NaOH
01/07/2021
Bài viết này chúng ta sẽ cùng đi tìm hiểu tổng quan về xút NaOH từ đặc điểm, tính chất, công dụng cho đến các loại xút đang được sử dụng phổ biến hiện nay.
Xem thêm ››
Top 4 loại NaOH được sử dụng phổ biến nhất hiện nay
01/07/2021
Xút NaOH là gì? Xút là gì? NaOH là chất gì? Top 4 loại NaOH được sử dụng phổ biến nhất hiện nay trên thị trường là loại nào, hãy cùng tìm hiểu cùng HTVLAB nhé.
Xem thêm ››
Hướng Dẫn Sử Dụng Tủ Sấy Phòng Thí Nghiệm - Tủ Sấy Memmert
01/07/2021
Tủ Sấy phòng thí nghiệm Memmert - Đức có cấu tạo và nguyên lý hoạt động như thế nào và cách sử dụng tủ sấy Memmert ra sao, hãy cùng tìm hiểu cùng HTVLAB qua bài viết sau nhé.
Xem thêm ››
ĐỘ C LÀ GÌ? ĐỘ F LÀ GÌ? CÁCH CHUYỂN ĐỔI ĐỘ C SANG ĐỘ F
26/06/2021
Trong hầu hết các ứng dụng đo nhiệt độ, người ta thường dùng đơn vị là độ C hoặc độ F. Vậy bạn có từng thắc mắc là độ C là gì? độ F là gì? Độ C và độ F khác nhau ra sao? Cách đổi độ C sang độ F cũng như là cách đổi từ độ F sang độ C?
Xem thêm ››
HƯỚNG DẪN SỬ DỤNG NỒI HẤP TIỆT TRÙNG AN TOÀN, KHOA HỌC
26/06/2021
Để nắm rõ hơn về chủ đề này, trước tiên ta cần tìm hiểu một số khái niệm về phương pháp tiệt trùng, thanh trùng sản phẩm, mục đích, nguyên lý, cấu tạo của các thiết bị thanh trùng, tiệt trùng, sau đó chúng tôi sẽ đưa ra 1 quy trình hướng dẫn sử dụng nồi hấp tiệt trùng tổng quan dựa trên nguyên lý chung đó để mọi người tham khảo và chia sẽ ý kiến cá nhân.
Xem thêm ››
Tại sao nên test nhanh mangan có trong nước?
26/06/2021
Test nhanh mangan có trong nước là phương pháp tất yếu không chỉ đối với những hộ gia đình mà còn đối với những khu công nghiệp, chăn nuôi. Vậy thì lý do tại sao nên sử dụng phương pháp test nhanh này?
Xem thêm ››
pH Của Nước Cất Và Giá Trị pH Trong Nước Cất
26/06/2021
pH là thước đo nồng độ ion hydrogen của dung dịch. Các dung dịch có nồng độ ion hydro cao có độ pH thấp và các dung dịch có nồng độ ion H + thấp có độ ph cao.
Xem thêm ››
CFU là gì? Cách tính CFU như thế nào?
26/06/2021
CFU là gì? Khi các nhà khoa học muốn biết có bao nhiêu vi sinh vật trong dung dịch vi khuẩn hoặc nấm, thường sẽ rất tốn thời gian để đếm từng tế bào riêng lẻ dưới kính hiển vi. Bằng cách pha loãng một mẫu vi khuẩn và cấy ria qua đĩa thạch Petri, các nhà vi sinh học có thể đếm các nhóm vi khuẩn mà được gọi chung là khuẩn lạc. Mỗi khuẩn lạc được cho là đã phát triển từ một đơn vị hình thành khuẩn lạc riêng rẽ (Colony Forming Unit – viết tắt là CFU).
Xem thêm ››
Máy Real Time PCR | Nguyên Lý và Quy Trình Vận Hành
26/06/2021
PCR/ Real-time PCR là những kỹ thuật ngày càng trở nên phổ biến trong công tác sinh học phân tử nhằm khuếch đại và cùng lúc xác định được số lượng của phân tử ADN mong muốn. Trong các phòng thí nghiệm xét nghiệm thủy sản, y học, trường ĐH, trung tâm nghiên cứu…. Bài viết hôm nay sẽ giới thiệu cho bạn cái nhìn tổng quang về một chiếc máy real-time PCR và một quy trình tổng quát khi làm việc với máy Real time PCR
Xem thêm ››
Cách Xử lý phèn trong ao nuôi tôm hiệu quả mà an toàn
23/06/2021
Cách xử lý phèn trong ao nuôi tôm bằng test kit Sera an toàn hiệu quả nhằm hạn chế tình trạng tôm chậm lớn, vàng mang, thậm chí gây chết rải rác, ảnh hưởng đến hiệu quả kinh tế của vụ nuôi.
Xem thêm ››
Hướng dẫn cách Xử lý nước thải trong ngành công nghiệp bạn cần biết
23/06/2021
Nước thải ngành công nghiệp thực phẩm hiện nay ảnh hưởng khá phức tạp đến môi trường. Vậy cách xử lý nước thải như thế nào? Cùng xem hướng dẫn trong bài viết.
Xem thêm ››
Dung Môi Methylene Chloride là gì? Tầm quan trọng của Methylene Chloride
23/06/2021
Dung Môi Methylene Chloride là gì? Tính chất vật lý và tầm quan trọng của Methylene Chloride trong đời sống như thế nào? Hãy cùng HTVLAB nghiên cứu trong bài viết này nhé!
Xem thêm ››
